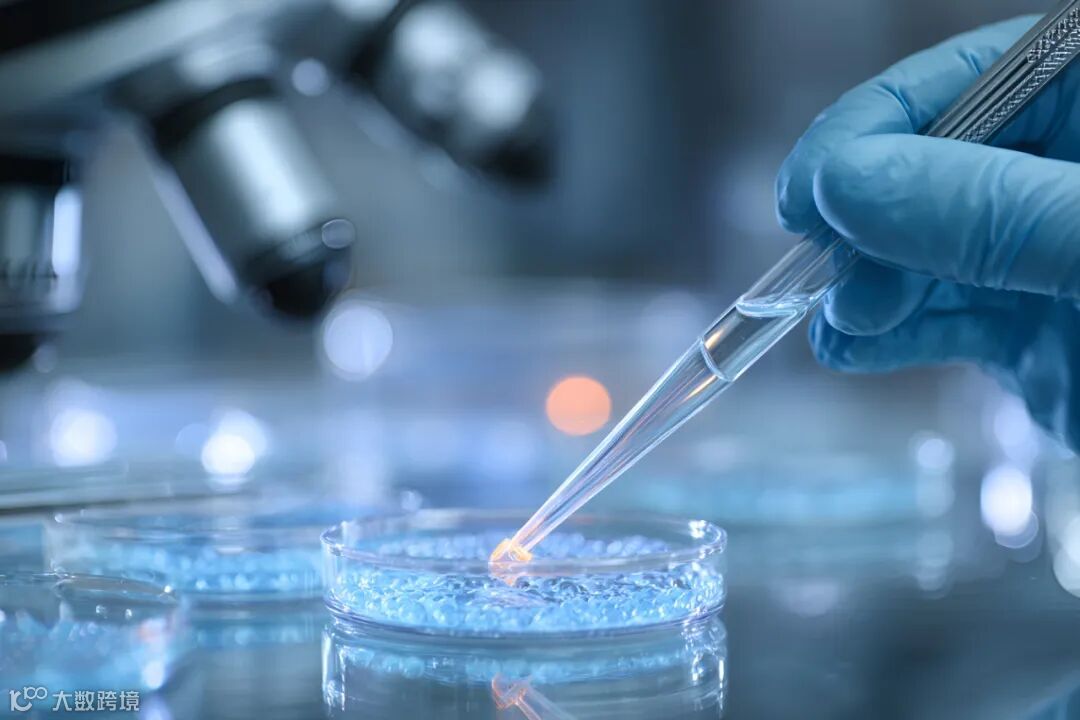

茅台加码合成生物,布局“食”“美”新赛道
茅台基金近日参与康维健生物B轮融资,联合普华资本、鼎晖投资、基石资本等多家机构共同注资。康维健生物成立于2019年,是一家专注于生物合成技术的平台型企业,业务覆盖化妆品原料、食品及保健食品领域,主打产品包括抗坏血酸棕榈酸酯、L-抗坏血酸棕榈酸酯等,官网显示其年营收达6500万元。

康维健生物简介,截自官网
此前,茅台基金已投资虹摹生物,后者于今年备案名为“岩藻糖基乳糖”的化妆品新原料(国妆原备字20250002),具备保湿、抗氧化、抗炎等多重活性。此次再度落子合成生物企业,进一步印证茅台正通过该技术路径延伸至美妆产业链。

全球领先技术获资本青睐
康维健生物拥有全球领先的生物酶法生产抗坏血酸棕榈酸酯生产线,厂区占地4万平方米,设计总产能3000吨,一期已建成1200吨/年产能。公司研发的“零排放”酯类酶法合成工艺属行业首创,因无同类技术,参与了国家标准制定。
目前拥有发明专利7项、实用新型专利10项,在申专利15项,技术秘密数十项。据《智药局》报道,其在江西龙南投资建设植物甾醇酯和酶制剂产线,总投资12亿元,一期投产后预计年主营业务收入超7.5亿元。

康维健生物旗下重点产品,截自官网
L-抗坏血酸棕榈酸酯被明确标注为“化妆品级”,具有抗氧化与美白功效,广泛应用于抗衰老及美白类化妆品中,同时也可用于保健品与药用辅料。凭借领先技术和多元应用场景,康维健生物在一年内完成四轮股权融资,投资者包括国投创合、茅台基金、普华资本、东方嘉富等头部机构。

截自企查查

茅台加速拓展美妆产业版图
尽管茅台投资康维健生物的核心逻辑在于其合成生物学的领先技术,但该技术在化妆品领域的广泛应用,无疑强化了茅台向“美”赛道延伸的战略意图。
除投资外,茅台集团自身也在积极布局。2023年申请的专利“一种酱香型白酒大曲抗菌多肽及其在制备抗炎药物中的应用”显示,相关成分可用于食品、化妆品或消杀剂的开发。
茅台学院——由茅台集团创办的本科高校,已与膜法世家合作推出“酱香酵母”(INCI名称:半乳糖酵母样菌发酵产物滤液)科研成果,并与全丽生物在酒糟提取物护肤应用、极端微生物抗衰老原料等领域开展长期合作。
茅台集团总经理王莉曾公开表示,茅台正利用合成生物学开辟生物经济新赛道,重点方向之一即“食”“美”赛道。依托庞大的微生物资源库,探索代谢路径并实现产业化,是茅台未来战略的重要组成部分。

合成生物学重塑美妆产业格局
合成生物学作为“第三次生物科学革命”的核心驱动力,正加速重构美妆产业。国家层面,《“十四五”生物经济发展规划》发布后,北京、上海、广东等地相继出台支持政策。深圳近期发布《深圳经济特区促进合成生物产业创新发展若干规定》,明确提出推动缩短合成生物产品入市周期,加强化妆品新原料领域的央地协同。
资本端,2025年前七个月合成生物学领域虽仅发生4起融资,但单笔金额显著提升,最高达1.5亿元,平均融资额同比增幅约260%。

企业方面,华熙生物运用第五代合成生物发酵技术赋能米蓓尔、夸迪等品牌;福瑞达实现王浆酸的国际首次合成生物产业化转化;上海家化于2025年3月成立合成生物创新研发中心,聚焦自主知识产权原料开发。
从政策引导到资本投入,再到技术落地,合成生物学正推动美妆产业进入新一轮变革周期。茅台的持续加码,不仅凸显其战略布局前瞻性,也为行业注入新的发展动能。









